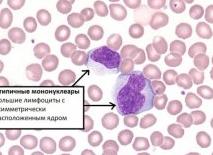
Атипичные мононуклеары в общем анализе крови у ребенка

[Атипичные мононуклеары в общем анализе крови у ребенка]
[Атипичные мононуклеары в общем анализе крови у ребенка]
атипичные мононуклеары в общем анализе крови у ребенка
Атипичные мононуклеары в крови: норма у детей
При общем анализе крови врач исследует концентрацию лейкоцитов, эритроцитов и тромбоцитов. Это кровяные тела, которые отвечают за свертываемость, цветовой показатель и защиту организма от инфекций. Они всегда находятся в организме человека, может лишь меняться их количество. Помимо нормальных клеток, каждая из которых играет свою роль, в крови человека могут появиться измененные клетки. Они сигнализирует, что в организм проникла инфекция или токсические вещества.
Что такое атипичные мононуклеары
Атипичные мононуклеары в крови у ребенка (их также принято называть вироцитами) — измененные клетки. По структуре и форме они напоминают лейкоциты и тромбоциты, однако в их строении присутствует всего одно ядро. В организме ребенка они содержатся в крайне низкой концентрации. Если врач выявляет их при общем анализе, диагностируется вирусная инфекция.
Повышенный процент вироцитов может сигнализировать о следующих патологиях:
- ветряной оспе или мононуклеозе;
- развитии опухолей (доброкачественных или злокачественных);
- ослаблении организма в результате приема антибиотиков;
- аутоиммунных болезнях;
- отравлениях токсическими веществами;
- заболеваниях крови.
Если атипичные мононуклеары в общем анализе крови выявлены у ребенка после вакцинации, беспокоиться о его состоянии не нужно. Выработка вироцитов — всего лишь ответная реакция на введение вируса.
Симптомы и внешние признаки повышенного уровня вироцитов
Распознать повышенный уровень атипичных мононуклеаров у детей возможно по следующим признакам:
- гипертермия (повышенная температура тела). Ртуть может достигать отметки 38 градусов и даже выше;
- усиленное выделение пота. Связано с изменением температуры;
- увеличение лимфатических узлов. Если вы прощупаете шею ребенка, то почувствуете узловые уплотнения, которые появились в этой области;
- болезненные ощущения в горле. Этот симптом говорит о набухании и покраснении небных миндалин. При детальном рассмотрении вы сможете обнаружить белый налет.
При медицинском обследовании ребенка врач выявляет изменение размеров печени и селезенки. Эти внутренние органы становятся значительно больше.
Как и зачем выявляют уровень мононуклеаров
Мононуклеары в анализе крови у детей выявляются в процессе общего (клинического) анализа крови. Клетки изучаются и подсчитываются в общем объеме биологического материала, соотносятся с другими клетками и выражаются в процентах. Такая процедура проводится в следующих случаях:
- при плановом профилактическом осмотре. Медицинское исследование проводится для того, чтобы исключить вероятность серьезных болезней на ранней стадии. Профилактический прием и медицинское обследование проводится 1 или 2 раза в год;
- при наличие жалоб. Ребенок может жаловаться на боли в горле, слабость и другие изменения в состоянии здоровья. В этом случае врач проводит анализ биологического материала, чтобы выявить, что именно привело к симптомам, о которых говорит ребенок;
- при обострения хронических болезней. Даже если врач полностью вылечил простуду или другую патологию, нет 100%-ой гарантии, что пациент не заболеет во второй раз. Если ребенок болеет слишком часто, врач анализирует состав крови. Это нужно для того, чтобы выявить наличие или отсутствие антител, отвечающих за защиту от инфекций.
Также кровь изучается перед вакцинацией или проведением операции. В процессе лечения общий анализ проводится для выявления активности лекарственных средств, назначенных для прохождения терапевтического курса.
Самая частая причина повышения вироцитов — вирус Эпштейна-Барра, который приводит к мононуклеозу (также его называют ВЭБ-инфекцией).
У детей до 1 года эта болезнь не развивается из-за пассивного иммунитета. Мальчики и девочки 7-10 лет напротив попадают в группу риска из-за снижения защитных функций. У детей этого возраста при исследовании крови выявляется до 50% вироцитов, а в запущенных случаях эта цифра может быть больше.
Болезнь развивается не сразу. В первые две или четыре недели вирус слабо проявляет себя. Поражение дыхательных путей проявляется по истечении инкубационного периода. Ребенок начинает жаловаться на сильную заложенность носа, общую слабость и болезненные ощущения в шее.
При первых симптомах отведите ребенка к врачу. Педиатр определит дальнейшие действия и проконсультирует вас о лечении детей в домашних условиях. Как правило, терапевтический курс проводится по следующим правилам:
- Врач назначает препараты, обладающие противовирусным, антисептическим и жаропонижающим действием. Антибиотики назначаются только при выявлении в биоматериале патогенных бактерий.
- Обеспечьте ваше чадо обильным питьем. Это нужно для того, чтобы вывести из организма продукты распада и облегчить его состояние.
- На время лечения нужно отказаться от тяжелых блюд: жареного, жирного, мучного и сладкого. Диета должна быть легкой и щадящей.
После завершения терапевтического курса врач снова проверяет кровь пациента. При анализе в крови у ребенка норма мононуклеаров должна быть не более 1%. Если показатели совпадают с медицинскими стандартами, педиатр заносит в историю болезни запись о выздоровлении.
Источник: pro-analiz.ru
Что обозначают атипичные мононуклеары в общем анализе крови
Постановке окончательного диагноза предшествует целый комплекс диагностических процедур. К ним относятся:
- сбор жалоб пациента,
- изучение истории возникновения заболевания, условий его проживания и работы,
- объективный осмотр,
- лабораторно-инструментальное исследование.
Остановимся подробнее на лабораторных анализах крови. А также выясним, для чего врачи назначают исследование на атипичные мононуклеары в общем анализе крови.
Возникает вопрос, что такое мононуклеары?
Это крупные одноядерные клетки лимфоидного ряда, похожие на нормальные клетки крови моноциты. Второе их название вироциты. Они относятся к группе фагоцитов и отвечают за защитные силы организма. Захватывают и уничтожают вирусы и болезнетворные бактерии, в результате чего становятся больших размеров. Их определяют в общем анализе крови (ОАК), который реагирует на любые болезненные состояния организма, особенно при подозрении на инфекционный процесс.
О чем говорит анализ на мононуклеары?
Он является точным показателем проблем со здоровьем. В норме у взрослого и ребенка их количество от 0-1% ко всем клеткам лейкоцитарного ряда. В ответе обычно обозначаются — ед.в пзр.
Их можно обнаружить с первых же дней заболевания. На 8-10-12 день их количество растет и составляет 10%. Это говорит о критической стадии заболевания и ее тяжелом течении. Такая высокая концентрация держится в течение 2-3 недель. Повторно уровень мононуклеаров в общем анализе крови определяется через неделю с целью отслеживания динамики заболевания и эффективности проводимого лечения. После же выздоровления их уровень может сохраняться высоким до 1,5 месяцев.
Как правильно сдать общий анализ крови на мононуклеары?
Существует алгоритм сдачи ОАК. Это:
- Анализ сдается утром строго натощак.
- Ограничение физических нагрузок накануне и в день сдачи анализа.
- За сутки до этого исключаются из рациона все сладкие, жирные и жареные блюда и алкоголь.
Как видно условия просты и легко выполнимы, но их необходимо соблюсти для получения достоверного уровня мононуклеаров в анализе крови.
Какие симптомы говорят о росте уровня мононуклеаров?
- Озноб, повышение tº > 38 ͦ,
- усиленное потоотделение,
- резкий упадок сил, слабость,
- тошнота,
- одутловатость лица,
- уплотнение и увеличение шейных лимфоузлов до 5см,
- катаральные явления в верхних дыхательных путях: отек носоглотки, осиплость голоса, затрудненное носовое дыхание, гнойные образования на задней стенки гортани,
- налет на миндалинах белесоватого цвета,
- боли в суставах и мышцах,
- увеличение селезенки и печени,
- пожелтение кожи и склер,
- изменение в лимфоцитарной формуле.
Факторы, способствующие появлению вироцитов в крови:
- инфекционные вирусные заболевания в острой форме,
- вакцинация.
Но при различного рода шоках, приеме некоторых гормональных препаратов, в частности глюкокортикоидов, пиогенных инфекциях происходит снижение их количества.
Так при каких же заболеваниях растет их содержание?
Пальма первенства принадлежит инфекционному мононуклеозу, а уже за ним следуют:
- ВИЧ;
- токсоплазмоз, вирус простого герпеса (ВПГ);
- онкологические заболевания;
- аутоиммунные процессы, в частности большая группа коллагенозов, таких, как системная красная волчанка (СКВ), ревматоидный и ревматический полиартриты;
- интоксикации в результате отравлений;
- нарушение в составе крови – различного вида анемии;
- внедрение в организм большого количества вирусов и болезнетворных бактерий.
Остановимся подробнее на инфекционном мононуклеозе.
Это заболевание вызывается вирусом Эпштейна-Барра. Источником инфекции является здоровый вирусоноситель и инфицированный больной. Чаще передается от больных с неясно выраженным клиническим течением, ввиду того, что они не обращаются к врачу и заболевание вовремя не диагностируется.
Пути передачи контактные, бытовые через предметы домашнего обихода – полотенца общего пользования, посуду. А также воздушно-капельный путь.
Инкубационный период, т.е. отрезок времени с момента заражения до появления первых симптомов, может длиться до 2-х месяцев.
Практика показывает, что у детей до года крайне редки случаи заболевания инфекционным мононуклеозом за счет врожденного пассивного иммунитета, полученного от матери. А чаще болеют дети от 7-10 лет и больше мальчики.
Длительность самого заболевания – 15-20 дней. Инфекция поражает лимфоузлы, носоглоточные миндалины, селезенку и, иногда, печень. Страдает в первую очередь вся иммунная система, т.к. она первой принимает на себя всю тяжесть удара. И на фоне ослабленного иммунитета зачастую присоединяется бактериальная инфекция с развитием таких осложнений как: пневмонии, ангины, отиты.
Ведущую роль в распознавании заболевания играют результаты, полученные в ходе лабораторных тестов. Они помогают точно установить окончательный диагноз, составить план и тактику ведения больного и проводить мониторинг эффективности лечения.
В течение года необходимо наблюдаться у гематолога и контролировать уровень мононуклеаров в крови.
Как можно предупредить повышение концентрации мононуклеаров в крови?
Специфической профилактики не существует. Есть только один путь – повысить иммунитет. Для этого необходимо:
- вести здоровый образ жизни,
- наладить правильное и сбалансированное питание,
- закаливать организм,
- заниматься спортом, ближним туризмом и плаванием.
Эти меры помогут значительно укрепить здоровье и жить активной наполненной жизнью.
Что обозначают атипичные мононуклеары в общем анализе крови
- сбор жалоб пациента,
- изучение истории возникновения заболевания, условий его проживания и работы,
- объективный осмотр,
- лабораторно-инструментальное исследование.
Возникает вопрос, что такое мононуклеары?
О чем говорит анализ на мононуклеары?
Как правильно сдать общий анализ крови на мононуклеары?
- Анализ сдается утром строго натощак.
- Ограничение физических нагрузок накануне и в день сдачи анализа.
- За сутки до этого исключаются из рациона все сладкие, жирные и жареные блюда и алкоголь.
Какие симптомы говорят о росте уровня мононуклеаров?
- Озноб, повышение tº > 38 ͦ,
- усиленное потоотделение,
- резкий упадок сил, слабость,
- тошнота,
- одутловатость лица,
- уплотнение и увеличение шейных лимфоузлов до 5см,
- катаральные явления в верхних дыхательных путях: отек носоглотки, осиплость голоса, затрудненное носовое дыхание, гнойные образования на задней стенки гортани,
- налет на миндалинах белесоватого цвета,
- боли в суставах и мышцах,
- увеличение селезенки и печени,
- пожелтение кожи и склер,
- изменение в лимфоцитарной формуле.
Факторы, способствующие появлению вироцитов в крови:
- инфекционные вирусные заболевания в острой форме,
- вакцинация.
Так при каких же заболеваниях растет их содержание?
- ВИЧ;
- токсоплазмоз, вирус простого герпеса (ВПГ);
- онкологические заболевания;
- аутоиммунные процессы, в частности большая группа коллагенозов, таких, как системная красная волчанка (СКВ), ревматоидный и ревматический полиартриты;
- интоксикации в результате отравлений;
- нарушение в составе крови – различного вида анемии;
- внедрение в организм большого количества вирусов и болезнетворных бактерий.
Остановимся подробнее на инфекционном мононуклеозе.
Как можно предупредить повышение концентрации мононуклеаров в крови?
- вести здоровый образ жизни,
- наладить правильное и сбалансированное питание,
- закаливать организм,
- заниматься спортом, ближним туризмом и плаванием.
Атипичные мононуклеары крови ребенка повышены
Что показывают атипичные мононуклеары в крови
Что показывают атипичные мононуклеары в крови? Этот вопрос интересен многим пациентам. Вариоциты называются атипичными мононуклеарами, они являются клетками белой крови, но имеют очень большую схожесть с моноцитами по своему строению. Строение ядра этих клеток не поделено сегментами, но уже окончило свое формирование, а это значит, что вариоциты для организма выступают активной защитой от вирусов и инфекций. При анализе крови их учитывают в процентном содержании, как и большинство других клеток крови.
Общий анализ крови — это один из самых лучших способов диагностирования различных видов болезней, того, как происходит взаимодействие между органами, и наблюдаются ли патологические или физические изменения. В общем анализе диагностика осуществляется благодаря наблюдению за форменными клетками крови, так как они способны менять свою структуру, форму, количество в зависимости от того или иного заболевания. К таким элементам и относятся атипичные мононуклеары.
Возникновение атипичных мононуклеаров
Мононуклеоз — это заболевание, возникающее от попадания в организм инфекционного воздействия, которое было вызвано вирусом четвертого, пятого и шестого типов.
Это заболевание имеет симптоматику: резкое повышение температуры вплоть до лихорадки, набухание лимфатических узлов, а также увеличение в размерах печени и селезенки.
Инфекционный мононуклеоз — это заболевание, при котором мононуклеары меняют свою форму, периферическую кровь и достигают пика изменения. Такая реакция называется умеренным лейкоцитозом, при котором увеличивается как количество, так и качество одноядерных составляющих крови.
Как только болезнь появляется в организме, происходит ряд серьезных изменений, количество сегментоядерного состава нейтрофилов резко падает, а вот количество палочкоядерных значительно повышается.
Самым первым симптомом при заболевании мононуклеозом инфекционного характера выступает увеличение размеров селезенки, причем увеличение может начаться даже в первый день заражения. Селезенка может продолжать расти до десяти дней, но есть и случаи, при которых селезенка продолжала увеличиваться 21 день. Самое тяжелое последствие такого роста заключается в том, что нельзя устранить или остановить увеличение с помощью хирургической операции.
Кроме увеличения селезенки, одними из первых признаков могут стать отечные процессы век, щек и шеи. Кожа также очень сильно страдает от болезни, на ней могут появляться всевозможные высыпания и раздражения, которые характерны у пациентов при скарлатине, кори и других заболеваниях.
Диагностика заболеваний
Так как заболевание напрямую связано с изменением состава крови, то не пострадать сердечно-сосудистая система просто не может. У пациентов нередко возникает тахикардия или приглушенное сердцебиение. Во время прослушивания сердца врач может отчетливо слышать систолический шум, но после выздоровление все приходит в норму.
Иных изменений ЭКГ показать не может. Общий анализ крови после болезни диагностирует нормализацию в крови лейкоцитов. Помимо всех этих симптомов в организме могут возникнуть атипичные мононуклеары, но их количество не превышает 50%, а зачастую значение колеблется в районе 15%. Процент атипичных мононуклеаров напрямую зависит от сложности болезни, с которой она протекает, и от вида инфекции.
Из этого делается вывод, что при выявлении в составе крови мононуклеаров атипичного характера можно диагностировать инфекционную болезнь, кроме того, данные элементы возникают в период пика болезни и способны сохранять свою деятельность на протяжении 20 дней. При последующем лечении болезни большую часть этих мононуклеаров вводят в состав Т-клетки.
Диагностика по атипичному признаку возможна, так как в цитоплазме их становится около 10%, но иногда случаются и пики, при которых их количество возрастает до 80%, но, несмотря на это, болезнь может протекать и без выявления этих клеток. Это объясняется тем, что в составе крови они могут образовываться в течение нескольких недель. Кроме того, их можно будет обнаружить даже на 5 неделе после выздоровления пациента.
Обследование пациента
Исследовав все эти параметры, врач может получить полную картину, как проходит мононуклеоз, как эффективно лечение, и что лучше использовать для терапии именно этого больного.
Кроме анализов крови могут потребоваться и другие, такие как: анализы мочи, ультразвуковое исследование, биохимические тесты и другие анализы, которые назначал врач.
Все это необходимо для того, чтобы определить, какова степень интоксикации организма, и где находится место, в котором происходит гнойно-воспалительный процесс.
Это дает возможность оценить индекс лейкоцитарной интоксикации, что является основным параметром для проведения контроля эффективности лечения, по динамике изменения можно прогнозировать пики болезни и сроки выздоровления.
Атипичные мононуклеары — это не отдельное заболевание, они выступают лишь одним из симптомов сильных инфекционных заболеваний человека, при котором значительно изменяется весь состав крови, происходит нарушение работы кровеносной системы. Поражаются участки кожи, и возникает большая температура.
Кроме того, такие симптомы требуют безотлагательного обращения в ближайшую больницу для проведения анализов, определения вирусов и назначения лечения, в противном случае последствия могут быть очень серьезными и привести даже к смерти пациента или инвалидности.
Атипичные мононуклеары могут проявиться и через три недели после заболевания инфекционным мононуклеозом, это нормально для организма. Наличие атипичных клеток может наблюдаться еще больше месяца в крови пациента, а их активность будет высокой на протяжении 20 дней, но переживать не о чем, так как со временем они сами пропадут, а особых проблем человеку не создадут.
Определить такое изменение клеток могут практически в любой лаборатории или медицинском заведении, лечение проводится долго, но в большинстве случаев без осложнений. Назначают анализы в случае повышения температуры, прощупывания селезенки и печени при подозрении на их увеличение. У детей чаще всего опухают щеки и веки.
Болезнь может коснуться абсолютно любого человека, который заразился серьезной вирусной инфекцией, но оно проходит бесследно, а организм быстро восстанавливается. И при повторном анализе врач не найдет абсолютно никаких отклонений.
Мононуклеоз (Изменения крови)
Инфекционный мононуклеоз. Гематологическая диагностика. Мазок периферической крови у здорового ребенка (а) и при инфекционном мононуклеозе (б); лейкоконцентрат у здорового ребенка (в) и при инфекционном мононуклеозе (г); х — атипичные мононуклеары.
Изменения крови. Инфекционный мононуклеоз сопровождается обычно умеренным лейкоцитозом (до 15 — 109/л — 20 — 109/л), иногда значительным. В ряде случаев заболевание может протекать с нормальным и даже уменьшенным числом лейкоцитов. Характерны увеличение одноядерных элементов крови и умеренно повышенная СОЭ (до 20 — 30 мм/ч). В начале болезни у большинства больных увеличено число палочкоядерных клеток крови. Самый характерный признак инфекционного мононуклеоза — наличие атипичных мононуклеаров. Одноядерные элементы крови морфологически представляют собой элементы округлой или овальной формы.
Размеры их варьируют от среднего лимфоцита до большого моноцита. Ядра клеток губчатой структуры с остатками нуклеол. Протоплазма широкая со светлым поясом вокруг ядра и значительной базофилией к периферии, в цитоплазме встречаются вакуоли. В связи с особенностями структуры атипичные моно нуклеары получили название широкоплазменные лимфоциты и монолимфоциты . При исследовании обычных мазков периферической крови больных инфекционным мононуклеозом атипичные мононуклеары, по нашим данным, выявляются в 86,5 % случаев.
Применяя метод концентрации лейкоцитов, атипичные мононуклеары удается обнаружить у всех больных. Атипичные мононуклеары чаще обнаруживаются в первые дни болезни, особенно в разгар ее, и только у некоторых больных они появляются через 1 — 1 нед. У большинства больных атипичные мононуклеары молено обнаружить в течение 2 — 3 нед от начала болезни, иногда они исчезают к концу 1 — й — началу 2 — й недели.
В 40 % случаев они продолжают обнаруживаться в крови в течение месяца и больше. Число атипичных мононуклеаров в крови больных инфекционным мононуклеозом колеблется в широких пределах — от 5 — 10 до 50 % и выше.
В единичных случаях в разгаре инфекционного мононуклеоза почти все мононуклеары оказывались атипичными. В разгар заболевания иногда наблюдаются различные высыпания на коже и слизистых оболочках. Сыпь на коже может быть точечной (скарлатиноподобной), пятнисто — папулезной (кореподобной), уртикарной, геморрагической. Энантема и петехии могут быть и на слизистой оболочке полости рта.
Инфекционные болезни у детей , Н.И.Нисевич
К списку публикаций раздела «Инфекционный мононуклеоз »
Мононуклеоз (Гепато) Инфекционный мононуклеоз. Типичный вид больного. Гепато-и спленомегалия:Гепато — и спленомегалия наблюдается в 97 — 98% случаев. Размеры печени начинают увеличиваться.
Мононуклеоз (Изменения сердца) Изменения сердца в виде тахикардии, небольшого приглушения тонов, систолического шума обычно нормализуются по мере выздоровления больного. Каких — либо серьезных.
Атипичные мононуклеары в периферической крови
Одновременно с лимфаденитом увеличиваются печень, селезенка. Нередко отмечаются диспепсические явления, боли в животе. У некоторых больных (у 5 — 10 %) отмечается небольшая иктеричность кожи и склер.
Иногда с помощью обычных лабораторных проб обнаруживаются незначительные нарушения функциональной способности печени. Может появляться пятнисто-папулезная, уртикарная или даже геморрагическая сыпь. Весьма характерны изменения со стороны крови, выявляющиеся с первых дней болезни, реже — в более поздние сроки.
В большинстве случаев отмечаются лейкоцитоз (от 15 * 10 9 /л до 30*10 9 /л, или 15 000 — 30 000 в 1 мм и выше) и увеличение количества одноядерных клеток, т. е. лимфоцитов и моноцитов. СОЭ умеренно повышена. Наряду с обычными лимфоцитами появляются атипичные зрелые одноядерные клетки среднего и крупного размера с широкой базофильной протоплазмой — атипичные мононуклеары (10 — 15 % и более).
Атипичные мононуклеары в периферической крови.
Наличие этих клеток в большом количестве весьма характерно для инфекционного мононуклеоза. Наблюдаются атипичные формы с характерной гематологической картиной или отсутствии других симптомов болезни.
Заболевание продолжается 2 — 4 нед, иногда дольше. Вначале исчезают лихорадка и ангина, а позже лимфаденит, увеличение селезенки и печени. Изменения со стороны крови у большинства больных исчезают одновременно с другими симптомами, но в некоторых случаях их ликвидация может затянуться на несколько недель и даже месяцев. У некоторых больных через несколько дней после снижения температуры возникает вторая волна ее повышения. Исход болезни, как правило, благоприятный.
Детские инфекционные болезни ,
С.Д. Носов
Инфекционный мононуклеоз Увеличение шейных лимфатических узлов (по Н. И. Нисевич). Лимфатические узлы достигают размеров крупной горошины, боба и даже грецкого ореха; они плотноваты, мало болезненны. Иногда в окружении их обнаруживается небольшой отек шейной клетчатки, нагноения не наблюдается. Часто нарушается носовое дыхание. Увеличиваются, но менее значительно также другие лимфатические узлы: подмышечные, паховые, локтевые.
Осложнения редки. Описаны отиты, пневмонии, стоматиты, серозные менингиты, нефриты.ДиагнозРаспознавание инфекционного мононуклеоза в ряде случаев представляет известные трудности. В практике нередко ставят ошибочные диагнозы: лакунарная ангина, фузоспириллезная и аденовирусная ангина, лимфаденит, дифтерия. Следует учитывать некоторые типичные черты заболевания: появление лимфаденита до развития ангины, поражение задне-шейных лимфатических.
Источники: https://osostavekrovi.ru/sostav/atipichnye-mononukleary-v-krovi.html, https://www.medkursor.ru/deti/infection/mononucleosis/497.html, https://www.kelechek.ru/detskie_infekcionnye_bolezni/infekcionnyy_mononukleoz_mononucleosis_infec/7898.html
Комментариев пока нет!
Атипичные мононуклеары в общем анализе крови: что это за клетки?
Атипичные мононуклеары – это специфические клетки иммунной системы, обнаруживаемые в крови при ряде заболеваний.
«Атипичные» означает, что клетки отличаются по строению от своих собратьев, «мононуклеары» от «mono» — один, «nucleus» — ядро. При обнаружении в мазке крови необычно крупных клеток с одним ядром, лаборатория указывает их наличие в бланке результата. Атипичные мононуклеары представляют собой ценную информацию для лечащего врача, облегчая ему процесс постановки диагноза.
Происхождение клеток
Атипичные мононуклеары относятся к семейству Т- и В-лимфоцитов – клеткам иммунной системы, отвечающим за защиту от вирусных инфекций, внутриклеточных паразитов и опухолевых клеток.
Т-лимфоциты образуются и в лимфатических узлах, после чего выходят в кровь и циркулируют в ней до полугода. Клетки обладают различными функциями:
- Т-киллеры (цитотоксические) – разрушают измененные клетки собственного организма, например, при опухолевой трансформации либо заражении внутриклеточными паразитами;
- Т-хелперы – сигнализируют об обнаружении чужеродных белков другим клетками иммунитета;
- Т-супрессоры – регулируют силу иммунного ответа.
В-лимфоциты образуются и созревают в костном мозге, после чего они выходят в кровяное русло и оседают в лимфоузлах, селезенке для дальнейшей дифференцировки. После контакта с чужеродным белком они активируются, начинают синтезировать защитные антитела — иммуноглобулины. В-лимфоциты обеспечивают обезвреживание возбудителей болезней и способствуют их выведению из организма.
Небольшая часть активированных В-лимфоцитов циркулирует в крови годами или пожизненно – они отвечают за иммунную память. Благодаря им в случае повторной встречи с той же самой инфекцией, иммунный ответ развивается в разы быстрее, чем в первый раз. Таким образом, заболевание не развивается вовсе или протекает в легкой форме.
В ответ на воздействие чужеродных белков на иммунную систему происходит активация лимфоцитов. Этот процесс сопровождается увеличением ядра и количества цитоплазмы, так как они вмещают большое количество синтезированных белков.
Некоторые вирусы способны напрямую усиливать синтетическую активность лимфоцитов, что приводит к образованию атипичных мононуклеаров. Такие изменения можно обозначить, как крайнюю степень активации лимфоцитов — они увеличивают в размере в 4-5 раз. В мазке крови атипичные мононуклеары выглядят, как клетки с широкой цитоплазмой и относительно небольшим ядром.
Норма крови у детей
В норме атипичные мононуклеары в крови детей не встречаются. Лимфоциты здорового ребенка имеют небольшой размер, компактное ядро и узкий ободок цитоплазмы вокруг него. По диаметру они схожи с эритроцитами, в то время, как атипично измененные клетки превышают их размер в 4-5 раз. Количество лимфоцитов в норме 10-40 000 клеток/л или 15-35% от общего числа лейкоцитов.
При каких заболеваниях появляются клетки?
Появление атипичных мононуклеаров связано с различными состояниями, такими как:
- вирусные инфекции (инфекционный мононуклеоз, ОРВИ, грипп, ветряная оспа, цитомегаловирусная инфекция, вирусные гепатиты в острой и хронической стадии, герпес, ВИЧ, коклюш);
- бактериальные инфекции (иерсиниоз, хламидиоз, туберкулез, сифилис, бруцеллез);
- паразитарные болезни (токсоплазмоз);
- вакцинация;
- опухоли;
- лекарственная непереносимость;
- аутоиммунные заболевания (системная красная волчанка, аутоиммунный васкулит).
Количество атипичных мононуклеаров выражают в процентах – считают их количество на 100 лейкоцитов. Анализ проводится в любой лаборатории, путем исследования окрашенного мазка крови под микроскопом.
Диагностика при инфекционном мононуклеозе
Наиболее часто появление атипичных мононуклеаров в крови связывают с Эпштейн-Барр вирусной инфекцией. Она передается воздушно-капельным путем и весьма широко распространена в человеческой популяции. Признаки перенесенной инфекции обнаруживают у 90% людей старше 25 лет. Иначе ее называют «поцелуйной болезнью», так как нередко заражение происходит во время поцелуя. Наиболее часто заболевают подростки и молодые люди.
Вирус Эпштей-Барра вызывает заболевание инфекционный мононуклеоз, название которого напрямую связано с изменениями в крови больного. Вирус связывается с мембраной лимфоцитов и передает ядру клетки сигнал, усиливающий активность клетки в десятки раз. Сам возбудитель в это время встраивается в ДНК лимфоцита.
В результате клетки приобретают крупный размер, активно синтезируют иммуноглобулины и, вместе с тем, белки вируса. Далее части вируса собираются в новые дееспособные вирусные частицы, покидают клетку и заражают другие лимфоциты.
Диагноз устанавливается на основании клинической картины в сочетании с микроскопическим исследованием мазка крови. Для больных характерно:
- повышение температуры тела до 38-39,0 С;
- боль в горле;
- налеты на миндалинах;
- затруднение носового дыхания;
- увеличение всех групп лимфоузлов, в том числе и в брюшной полости, что может привести к острым болям в животе;
- увеличение печени и селезенки;
- желтуха;
- сыпь на коже (она возникает в 95% случаев после приема антибиотика ампициллина);
- слабость, недомогание.
Наиболее типичные признаки болезни — это ангина в сочетании с увеличением лимфоузлов не только на голове и шее, но и в других областях тела.
Диагноз подтверждают двумя общими анализами крови, выполненными с интервалом в 5 дней, при обнаружении в каждом из них более 10% атипичных мононуклеаров. Количество их постепенно нарастает и достигает максимума (до 60-80%) к десятому дню болезни.
Нормализация показателей крови происходит медленно, в течение месяца. Так же длительно сохраняется астенический синдром – слабость, потливость, раздражительность, сонливость. Если количество атипичных мононуклеаров в этот срок не уменьшается, то следует исключить опухолевую природу изменений.
Описанная клиническая картина характера для острого периода заболевания. Вирус Эпштен-Барра сохраняется в лимфоцитах пожизненно, но реактивация инфекции возможна лишь в случаях резкого снижения иммунитета (ВИЧ-инфекция и иные синдромы приобретенного иммунодефицита). У детей с нормальным иммунитетом вирус находится в подавленном состоянии и болезненных проявлений не вызывает. В-лимфоциты после перенесенной инфекции синтезируют иммуноглобулины (IgG) а белкам вируса Эпштейн-Барра в течение длительного времени, поэтому они могут быть обнаружены в крови методом ИФА даже спустя несколько лет.
Принято связывать наличие атипичных мононулеаров только с инфекционным мононуклеозом, но это неверно. Обнаружение подобных клеток в крови не позволяет сразу поставить диагноз, так как они встречаются при различных заболеваниях. Их наличие говорит лишь о факторе, вызывающем активацию лимфоцитов.
Какой именно процесс является причиной изменений должен выяснять врач на основании осмотра больного и уточняющих анализов. Он может дополнительно назначить биохимический анализ крови, УЗИ брюшной полости, лимфоузлов, анализ крови ИФА и ПЦР методом для косвенного или прямого обнаружения возбудителя болезни, пункцию лимфоузла и костного мозга.
загрузка…
Атипичные мононуклеары в общем анализе крови у ребенка
Главная » Анализ крови » Атипичные мононуклеары в общем анализе крови у ребенка
Всем родителям известно, что в крови ребенка присутствуют такие клетки, как эритроциты и лейкоциты, а также тромбоциты. Многие мамы также знают, что лейкоциты представлены разными видами, а определение их уровня в процентах составляет лейкоцитарную формулу.
Все эти клетки находятся в кровотоке ребенка в норме. Однако помимо нормальных клеток в анализе крови детей могут появляться и измененные, подсказывая родителям и врачам, что у ребенка имеется определенная болезнь. Одними из таких измененных клеток крови выступают атипичные мононуклеары. Посмотрите интересное видео, в котором знаменитый детский доктор Комаровский подробно разъясняет, что такое клинический анализ крови: Атипичными мононуклеарами (другое их название — «вироциты») являются измененные одноядерные клетки крови. По строению и функции вироциты можно отнести к белым клеткам крови. У таких клеток есть схожесть с нормальными одноядерными клетками — моноцитами и лимфоцитами.
В атипичных мононуклеарах есть одно ядро, которое отличается полиморфизмом и губчатой структурой. Форма таких клеток является круглой или овальной. В зависимости от состава цитоплазмы и размеров эти клетки делят на моноцито- и лимфоцитоподобные.
По мнению многих ученых, атипичные мононуклеары происходят от Т-лимфоцитов. Они вырабатываются в ответ на проникновение вирусов в детский организм или под влиянием других факторов.
Атипичные мононуклеары под микроскопом
Выявление атипичных мононуклеаров в детском возрасте происходит во время проведения клинического анализа крови, включающего лейкограмму. Такие клетки подсчитываются в анализируемом объеме крови, сравниваются с числом всех лейкоцитов и выражаются в процентах. Ребенка направляют на такой анализ:
- Планово, чтобы убедиться в отсутствии скрыто протекающих болезней.
- При наличии жалоб, а также, если врач заподозрил инфекцию на основе осмотра.
- Во время подготовки к операции, а в некоторых случаях – перед вакцинацией.
- При обострении хронических патологий.
- В процессе лечения, чтобы удостовериться в его эффективности либо неэффективности.
Выявить атипичные мононуклеары можно, сдав на анализ кровь из пальца малыша В нормальном анализе крови ребенка атипичных мононуклеаров зачастую нет, но присутствие единичных клеток такого типа не считается патологией, поэтому нормой для детского возраста называют 0-1% вироцитов от числа всех белых клеток крови.
Наиболее часто уровень атипичных мононуклеаров повышается при вирусных заболеваниях, например, при ветряной оспе. Повышенный процент вироцитов также выявляют при:
- Опухолевых процессах.
- Аутоиммунных заболеваниях.
- Патологиях крови.
- Отравлениях.
- Длительном приеме некоторых лекарственных средств.
Следует отметить, что в большинстве случаев такие клетки не превышают 10% от всех лейкоцитов. Если же атипичных мононуклеаров в лейкоцитарной формуле анализа крови детей выявляют больше десяти процентов, это является поводом диагностировать у ребенка болезнь под названием «инфекционный мононуклеоз». Поскольку ее причиной является вирус Эпштейна-Барр, такое заболевание также называют ВЭБ-инфекцией.
При такой инфекции атипичные мононуклеары выявляются в крови ребенка всегда. Болезнь чаще диагностируют у детей старше года, а ее инкубационный период может составлять до двух месяцев, а заразиться можно как при прямом контакте с болеющим ребенком, так и воздушно-капельным путем. При данной патологии уровень атипичных мононуклеаров может достигать 50% от всех лейкоцитов, а в некоторых случаях даже бывает выше.
При ВЭБ-инфекции у ребенка болит горло, воспаляются лимфоузлы и повышается температура Болезнь поражает лимфоидную ткань, поэтому у деток с инфекционным мононуклеозом диагностируют воспаление миндалин, лимфоузлов, селезенки, печени. Первыми симптомами патологии выступают высокая температура тела, увеличение лимфатических узлов, сильные боли в горле, заложенность носа. Вироциты появляются в крови заболевшего ребенка не сразу, а лишь спустя две-три недели. Кроме того, они остаются в кровотоке детей в течение пяти-шести недель после выздоровления.
Если анализ крови ребенка показал высокое содержание атипичных мононуклеаров, это является поводом обращения к врачу. Педиатр оценит общее состояние малыша, а также перенесенные болезни, поскольку после недавней вирусной инфекции уровень вироцитов в крови бывает повышенным еще несколько недель.
Подтвердив наличие у ребенка ВЭБ-инфекции, ему назначат симптоматическую терапию, включающую жаропонижающие, общеукрепляющие, антисептические и другие препараты. Специфического лечения, воздействующего на вирус Эпштейна-Барр, не существует.
В большинстве случаев прогноз ВЭБ-инфекции благоприятный и многие дети переносят ее в легкой форме. Лишь у некоторых детей возникают такие серьезные осложнения, как гепатит, разрыв селезенки или отек гортани.
При поражении печени ребенка переводят на специальную щадящую диету, дополняя ее лекарствами с гепатопротекторным и желчегонным действием. Если присоединилась бактериальная инфекция, показано применение антибиотиков и пробиотиков. При тяжелом течении или осложнениях ребенку могут назначаться гормональные средства, удаление селезенки, трахеостомия или искусственная вентиляция легких.
При ВЭБ-инфекции в неосложненных случаях проводится симптоматическое лечение
www.o-krohe.ru
Атипичные мононуклеары (вироциты) в крови у взрослых и детей
Атипичные мононуклеары или вироциты — разновидность лимфоцитов, клеточная структура которых имеет сходство с моноцитами. Они имеют одноядерное строение. Появление в крови может указывать на развитие инфекционного вирусного заболевания. Если при этом наблюдается изменение количественного показателя крови, это указывает на прогресс вируса в организме.
Важно! В данном случае проводится дополнительное обследование, так как атипичные мононуклеары характерны для инфекционного мононуклеоза.
Факторы появления вироцитов в крови
Причиной возникновения мононуклеарных клеток в крови является попадание в организм человека вирусной инфекции.
Важно! Когда человек полностью здоров, атипичные мононуклеары в крови составляют минимальный процент или вовсе отсутствуют.
Когда уровень вироцитов в анализе крови составляет более 10%, данное состояние может спровоцировать:
- инфекционное, вирусное заболевание в острой форме (в частности, мононуклеоз, ветряная оспа);
- вакцинация (как ответная реакция организма на введение фрагментов вируса).
Примечание: мононуклеары атипичные в начале развития патологии увеличивают свою численность вместе с другими видами клеток (палочкоядерными нейтрофилами), в то время как концентрация сегментоядерных клеток уменьшается.
Атипичные мононуклеары в крови у ребенка, как правило, вызваны вирусом Эпштейна-Барра, поражающим верхние дыхательные пути, шейные лимфоузлы. Высокая концентрация вирусных клеток наблюдается на поверхности глотки, в тканях печени, селезенки, лимфоузлах. Поэтому после инкубационного периода, длящегося от 5 до 15 суток, нередко отмечается увеличение размеров селезенки и печени.
Инфекционный мононуклеоз причисляют к вирусам группы герпесов 4 типа.
Симптомы, характерные при увеличении уровня мононуклеарных клеток у детей
Дети первого года жизни наименее подвержены заболеванию Эпштейна-Барра. Объясняется это наличием врожденного пассивного иммунитета к данному вирусу. Однако у детей в 7–10 лет отмечается снижение защитных функций организма, в связи с чем у пациентов данной возрастной группы нередко обнаруживаются атипичные мононуклеары в общем анализе крови. В этом возрасте зарегистрировано наибольшее число заболеваний инфекционным мононуклеозом.
Симптомы, которые являются признаком повышения вироцитов в крови у ребенка:
- гипертермия (высокая температура тела — 380 и выше);
- усиленное потоотделение;
- уплотнение, увеличение лимфатических узлов (в шейной области);
- налет белого цвета на миндалинах;
- набухание небных миндалин;
- количественное изменение химического состава крови (изменение лимфоцитарной формулы);
- увеличение размеров печени, селезенки.
Вас также могут заинтересовать нормы содержания лимфоцитов в крови у женщин и прочитать о них можно в следующей статье на нашем портале.
Примечание: согласно статистическим данным более подвержены инфекционному мононуклеозу мальчики в возрасте до 10 лет.
Признаками инфицирования может быть кожная сыпь, имеющая петихиальный характер и различную локацию.
Признаки повышения атипичных мононуклеаров у взрослых
Клинические проявления начальной стадии патологии у взрослых:
- упадок сил;
- тошнота;
- катаральные явления — отечность носоглотки, затрудненное носовое дыхание, сиплость голоса, прочее;
- гнойные образования на задней стенке гортани;
- озноб, резкое повышение температуры;
- ноющая боль в суставах, мышцах.
Основными проявлениями патологий, при которых возрастает численность атипичных мононуклеаров, являются:
- проявления интоксикации (тошнота, потоотделение, озноб, прочее);
- набухание лимфоузлов;
- одновременно увеличение размеров селезенки, печени;
- мигрень;
- усиление боли в суставах, мышцах;
- появление симптомов ангины (гиперемии слизистой неба, желтый налет рыхлой структуры на небных миндалинах, боль в горле).
Примечание: может наблюдаться отечность лица по причине нарушенного лимфооттока. Лимфоузлы могут увеличиваться до 5 см в диаметре. При пальпации болезненные ощущения либо незначительны, либо вовсе отсутствуют.
В активной фазе мононуклеоза увеличивается печень и селезенка. При этом нередко возникает желтушный синдром со следующими проявлениями:
- тошнота, доходящая до рвоты;
- снижение, отсутствие аппетита;
- изменение цвета мочи (потемнение, мутность);
- тянущая боль, чувство распирания в подреберье с правой стороны;
- желтый оттенок кожных покровов, глазного белка;
- расстройство стула (запор, диарея).
Спустя 10-12 дней после появления первых симптомов по телу может распространиться пятнисто-папулезная сыпь неопределенной локализации, которая не вызывает зуда.
Болезни, при которых возрастает уровень атипичных клеток
Атипичные мононуклеары в общем анализе крови являются признаком инфекции в организме. Точный диагноз можно установить исходя из следующих критериев форменных клеток:
- изменение структуры и формы;
- увеличение количества;
- изменение процентного соотношения между разными видами клеток.
Примечание: содержание вироцитов в пределах 10-15% с большой вероятностью указывает на развитие инфекционного мононуклеоза.
При каких заболеваниях характерны атипичные мононуклеары? Это может быть токсоплазмоз, вирус герпесной группы, ВИЧ, онкологические патологии, прочее.
Нередко отмечается превышение нормы содержания после введения вакцины у детей.
Видео-передача «Жить здорово» о симптомах и лечении инфекционного мононуклеоза
Показатели мононуклеаров в крови
Анализ крови на атипичные мононуклеары сдают при подозрении на наличие какого-либо инфекционного, вирусного заболевания. Мононуклеарные клетки могут содержаться в лимфоцитарной крови здорового человека в силу особенностей организма. Однако их концентрация не должна превышать 1/6 части от общей численности лимфоцитов.
Примечание: если наблюдается динамика роста показателя, следует сдать повторный анализ.
Современной медициной признана норма мононуклеарных клеток у детей первого года жизни в пределах до 1%. Также значение может держаться на высокой отметке (до 10 и более процентов) спустя 1-1,5 месяца после перенесения мононуклеоза. Данное остаточное явление считается нормой.
Мононуклеарные клетки играют для человеческого организма важную роль, выполняя свою основную функцию — борьбу с возбудителями инфекционных заболеваний. Поэтому их появление может стать сигналом об ухудшении здоровья. При обнаружении вироцитов необходимо срочно обращаться за консультацией к врачу, чтобы избежать серьезных осложнений.
Рекомендуем изучить похожие материалы:
- 1. Система гемостаза: зачем сдавать анализ на свёртываемость крови
- 2. Аутоиммунная гемолитическая анемия у детей: чего не хватает и как проявляется
- 3. Как подобрать диету по группе крови: худеем вместе
- 4. Причины и опасности повышения уровня базофилов у детей
- 5. Понизился уровень базофилов у взрослых: как лечить базофилию
- 6. Причины повышения или понижения нейтрофилов в анализе крови у детей?
- 7. Нормы содержания нейтрофилов в крови и какие функции они выполняют
moyakrov.ru
Атипичные мононуклеары в крови: норма у детей
Что такое атипичные мононуклеары
- ветряной оспе или мононуклеозе;
- развитии опухолей (доброкачественных или злокачественных);
- ослаблении организма в результате приема антибиотиков;
- аутоиммунных болезнях;
- отравлениях токсическими веществами;
- заболеваниях крови.
Симптомы и внешние признаки повышенного уровня вироцитов
- гипертермия (повышенная температура тела). Ртуть может достигать отметки 38 градусов и даже выше;
- усиленное выделение пота. Связано с изменением температуры;
- увеличение лимфатических узлов. Если вы прощупаете шею ребенка, то почувствуете узловые уплотнения, которые появились в этой области;
- болезненные ощущения в горле. Этот симптом говорит о набухании и покраснении небных миндалин. При детальном рассмотрении вы сможете обнаружить белый налет.
Как и зачем выявляют уровень мононуклеаров
- при плановом профилактическом осмотре. Медицинское исследование проводится для того, чтобы исключить вероятность серьезных болезней на ранней стадии. Профилактический прием и медицинское обследование проводится 1 или 2 раза в год;
- при наличие жалоб. Ребенок может жаловаться на боли в горле, слабость и другие изменения в состоянии здоровья. В этом случае врач проводит анализ биологического материала, чтобы выявить, что именно привело к симптомам, о которых говорит ребенок;
- при обострения хронических болезней. Даже если врач полностью вылечил простуду или другую патологию, нет 100%-ой гарантии, что пациент не заболеет во второй раз. Если ребенок болеет слишком часто, врач анализирует состав крови. Это нужно для того, чтобы выявить наличие или отсутствие антител, отвечающих за защиту от инфекций.
- Мононуклеары в общем анализе крови
Мононуклеоз у ребенка
- Врач назначает препараты, обладающие противовирусным, антисептическим и жаропонижающим действием. Антибиотики назначаются только при выявлении в биоматериале патогенных бактерий.
- Обеспечьте ваше чадо обильным питьем. Это нужно для того, чтобы вывести из организма продукты распада и облегчить его состояние.
- На время лечения нужно отказаться от тяжелых блюд: жареного, жирного, мучного и сладкого. Диета должна быть легкой и щадящей.
pro-analiz.ru
Уровень атипичных мононуклеаров в общем анализе крови, когда стоит бить тревогу?
Всегда ли мононуклеары, найденные врачом в общем анализе крови, считаются сигналом патологического состояния, и как они обозначаются? При каких болезнях увеличивается число атипичных клеток? Как диагностировать инфекционный мононуклеоз – об этом пойдет речь в данной статье.
Роль мононуклеаров в организме
Мононуклеары или агранулоциты – это одноядерные клетки, отвечающие за иммунные реакции. Они делятся на моноциты и лимфоциты. Первые при поступлении в систему вредоносных вирусов и бактерий поглощают их и распространяют сигнал о вторжении чужеродных клеток. Лимфоциты же продуцируют антитела для борьбы с инфекцией.
Иммунитет ко многим вирусам вырабатывается благодаря В-лимфоцитам, циркулирующим в организме в течение полугода и более. Формируется иммунная память, чтобы при следующей встрече с возбудителями болезнь переносилась легче.
Есть группы вирусов, которые способны усилить синтетическую активность лимфоцитов, что впоследствии приведет к образованию атипичных мононуклеаров. Размер клеток увеличивается в 4-5 раз, при рассмотрении под микроскопом заметна широкая цитоплазма и небольшое по величине ядро.
Атипичные мононуклеары в общем анализе крови часто становятся сигналом наличия серьезных болезней как у взрослых, так и у детей.
Атипичные клетки могут говорить о заболевании, поэтому важно проводить диагностику
Причины появления в крови атипичных клеток
Возникновению атипичных мононуклеаров способствуют заболевания, выводящие из строя иммунную систему организма. Среди наиболее вероятных причин выделяют:
- заболевания вирусного характера (инф. мононуклеоз, ОРВИ, грипп, ветрянка, цитомегаловирусная инфекция, болезнь Боткина, ВИЧ-инфицирование, коклюш);
- болезни бактериального характера (иерсиниоз, хламидиоз, туберкулез, бруцеллез);
- заражение гельминтами;
- онкология;
- индивидуальная непереносимость мед.препаратов;
- болезни аутоиммунного типа (красная волчанка, васкулит).
Вирус инфекционного мононуклеоза
Чаще других факторов появление патологических клеток провоцирует вирус Эпштейн-Барра. Заражение им происходит через воздух при общении с больным или носителем. Возможен плацентарный путь передачи от матери к ребенку и в результате незащищенного полового акта.
Вирусному заболеванию больше подвержены дети подросткового возраста и молодые люди. По статистике, к 25 годам почти 90% населения перенесли инфекционный мононуклеоз, вызванный данным вирусом.
Характерной особенностью становится поражение лимфоидной ткани при заболевании: это миндалины, печень, селезенка, все лимфатические узлы.
Симптомы мононуклеоза:
- повышение температуры тела до 38,5-39,0 °С;
- болевые ощущения при глотании;
- симптомы общей интоксикации;
- налет на миндалинах;
- заложенность носа, храп;
- увеличенные лимфоузлы, особенно шейные;
- пожелтевшие склеры и кожа;
- увеличение размеров печени и селезенки.
Инкубационный период болезни может длиться от 5 дней до 2 месяцев. По совокупности признаков клиническая картина напоминает ангину.
Ангина + сильный отек носоглотки + увеличение печени + мононуклеары в крови = мононуклеоз. Вирус размножается делением клеток с высокой скоростью, однако во внешней среде он неустойчив. Болезнь у большинства людей протекает в легкой форме.
Характерная симптоматика заболевания для большинства детей и взрослых
Именно поэтому диагностика ее затруднена. Анализ забора крови на мононуклеары может быть назначен врачом с диагностической целью при первичном обращении к нему пациента.
Нормы показателей у детей
Норма увеличенных в размере агранулоцитов в крови ребенка составляет 0-1%. Незначительно (до 10%) их число увеличивается при аутоиммунных болезнях, опухолях. Наибольший уровень атипичных мононуклеаров в ОАК у ребенка присутствует при инфекционном мононуклеозе. Иногда их число превышает 50% белых клеток крови.
Для подтверждения диагноза кровь берут дважды с интервалом в пять дней. На начальной стадии заболевания количество атипичных клеток составляет 10%. Через неделю число достигает максимума – 60-80%.
Как определить мононуклеары при диагностике
Если обнаружены атипичные мононуклеары в ОАК, обозначение их может трактоваться врачом в процентах или единицах СИ. В зависимости от предварительного диагноза и состояния больного он может отдать предпочтение нескольким методам:
Данные клетки крови обнаруживаются при расшифровке лейкоцитарной формулы. Таблица показателей включает все типы клеток. Формула содержит процентное содержание всех лейкоцитов, отдельно моноцитов и лимфоцитов.
Положительный анализ крови на атипичные мононуклеары подтверждает диагноз, определяет степень тяжести инфекции и эффективность назначенного лечения.
Важно! Обнаружить атипичные клетки таким способом можно только на ранней стадии, через две недели после заражения вирусом.
Сдать анализ можно в медицинском диагностическом центре.
Гемотест – это обнаружение в сыворотке крови больного антител к возбудителю методом агглютинации. Эффективность метода составляет 90%.
- Дополнительные методы диагностики.
Вспомогательными методами диагностики является анализ мочи – в биохимическом анализе обнаруживается высокое количество билирубина, АЛТ, АСТ. Это происходит из-за увеличения секреции желчи. Впоследствии желтеют кожные покровы и склеры глаз. Врач может назначить УЗИ органов брюшной полости, провести пункцию костного мозга или лимфоузла.
Исследуется кровь инвитро (анализ а пробирке)
Процесс восстановления после продолжительной болезни достаточно длительный и трудоемкий. На протяжении месяца наблюдается астения – повышенная раздражительность, усталость, потливость. К концу восстановительного периода нормализуется уровень анализов на мононуклеары.
Обратите внимание, если через месяц количество патологических клеток не приходит в норму, нужно проконсультироваться у врача онколога. При обнаружении атипичных мононуклеаров в общем анализе крови у ребенка необходимо поставить его на учет к онкологу.
Вирус присутствует в лимфоцитах на протяжении всей жизни, но в пассивном состоянии. Его активация происходит только в случае аутоиммунного заболевания или ВИЧ-инфекции в связи с падением иммунитета.
Лечение
Лечение инфекционного мононуклеоза симптоматическое. Покой, свежий воздух, обильное питье, обработка ротоглотки, промывание носа – стандартная терапия вирусной инфекции. После перенесенной болезни ребенок длительное время остается ослабленным, поэтому врач оформляет медотвод от прививок на 6-12 месяцев.
Противопоказаны в восстановительный период дальние путешествия со сменой климата, нельзя загорать. Антибиотики назначаются в случае присоединения бактериальной инфекции: отита, пневмонии.
Своевременное обращение к врачу гарантирует успешное лечение, минимизирует риск осложнений.
В предложенном видеосюжете об этом рассказано подробнее:
lechiserdce.ru